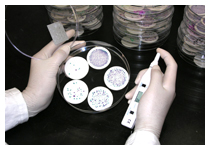
Counting E. coli colonies on filter membrance

Collecting beach water at Hung Shing Yeh Beach in 1980s
Counting
E. coli colonies on filter membrance
E. coli colonies on filter membrane

Field measurement

Field measurement

Incubating filter membrane

Interviewing beach visitors in an earlier study

Performing membrane filtration

Performing membrane filtration

Registration of microbiological samples

Sampling and field measurement

Sampling and field measurement

Sampling at Silvermine Bay Beach

Sampling at a storm channel in Deep Water Bay Beach

Sampling at a storm outlet in Repulse Bay Beach

Sampling at Repulse Bay Beach in 1990s

Staff attending training workshop